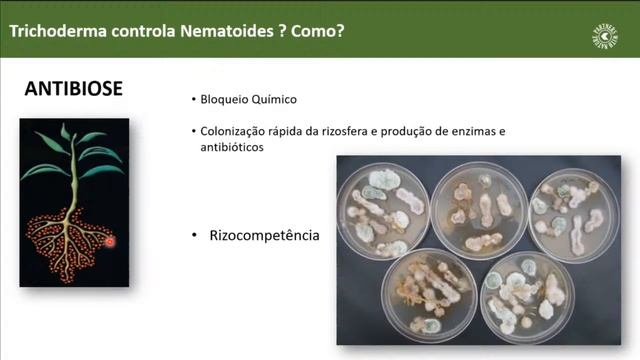
Uso De Biológicos En El Control De Hongos Del Suelo Y Nematodos

Магия грибов: лесные открытия - Новые видео
-
-
खेती में Trichoderma का प्रयोग Use Of TRICHODERMA In Agriculture Organic Farming @HELLO FARMING
In this video I have tried to give a complete Information about Trichoderma viride bio fungicide. Watch this video till the end, all of your doubt and Q...
Смотреть -
Medical Vocabulary: What Does Animal Migration Mean
What does Animal Migration mean in English?
Смотреть -
-
-
Fit Banki - Гриб бочки
не воспринимайте это серьезно #трэк #рэп #реп #трек #песня #бит #хочукушать
Смотреть -
Sleek MakeUp Eyeshadow Palettes Review
If you find this video useful, please give it a "Like" and subscribe if you already haven't. Check out some of my other videos, I would appreciate it so...
Смотреть -
-
Новости Гродно. Памятник Алексею Антонову. 17.08.2021
ТРК Гродно. Новости Гродно и Гродненского региона на канале Беларусь 4 Гродно. Телевидение Гродно - http://tvgrodno.by #НовостиГродно #Навіны #Беларусь4...
Смотреть -
-
-
-
Весна пришла , дела пошли уборка весь в бегах
Контакты для канала дзен http:|/dzen.ru/id/ Яндекс дзен https://zen.yandex.ru/id/62221b4045650202fbcd34fe для развития канала помощь ...
Смотреть -
[Diamond-RP Emerald] Рядовой Requeste [Часть #1]
Подписывайтесь ставьте палец вверх! Всем мир подписюнята.
Смотреть -
Простой и очень вкусный салат #готовим дома #простые рецепты #вкусные салаты #shorts
Простой и очень вкусный салат.
Смотреть -
-
-
-
Perenteryl, ¡La Diarrea Para, Tú No!
El probiótico antidiarreico para toda la familia. ¡La diarrea para, tú no!
Смотреть -

![[Diamond-RP Emerald] Рядовой Requeste [Часть #1]](https://pic.rtbcdn.ru/video/2025-02-03/a6/10/a6101bab4e08acdd5e2410371854dd26.jpg)





